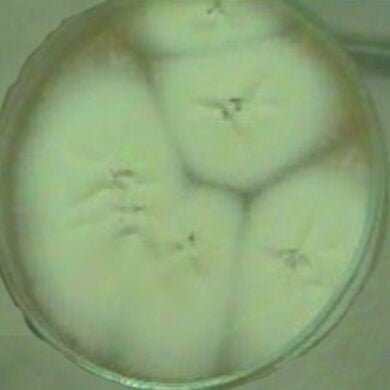

بحوث علمية وأطاريح
-

تحديد البصمة الوراثية لستة من أصناف نخيل التمر Phoenix dactylifera L. باستعمال المؤشرات الجزيئية للتضاعف العشوائي متعدد الاشكال RAPD-PCR
[googlepdf url=”https://iraqi-datepalms.net/wp-content
أكمل القراءة » -

تأثير رش الاشجار بمنظمات النمو النباتية في محتوى الاوراق والثمار من الهرمونات النباتية والإنزيمات المضادة للأكسدة وبعض صفات نخيل التمر في محافظة البصرة 2018
[googlepdf url=”https://iraqi-datepalms.net/wp-content
أكمل القراءة » -

-

-

-

Evaluation of the Entomopathogenic Fungi Metarhizium anisopliae and Beauveria bassiana against the Red Palm Weevil Rhynchophorus ferrugineus
G. Gindin S.Levski I. Glazer V. Soroker
أكمل القراءة » -

Injector-size and the time of application affects uptake of tree trunk-injected solutions
M.A. Sanchez Zamora, R. Fernandez Escobar
أكمل القراءة » -

Estimating transpiration in an intercropping systems measuring sap flow inside the oasis
Mohamed Habib Sellami, Mohamed Salah Sifaoui
أكمل القراءة » -

-

-

-

سوسة النخيل الحمراء في مناطق البحر المتوسط
[googlepdf url=”https://iraqi-datepalms.net/wp-content
أكمل القراءة » -

The Use of RAPDs Technique for the Detection of Genetic Stability of Date Palm
Saleh M. Bader , Michael Baum , Hussam. S. M. Khierallah an
أكمل القراءة » -

كفاءة الفطر Beauveria bassiana والمبيد Avaunt في مكافحة دودة ورق القطن Spodoptra littoralis (Boisd.) (Lepidoptera: Noctuidae)
شيماء حميد مجيد العبيدي جامعة بغداد / كلية الزراعة / قسم وقا
أكمل القراءة » -

تأثير طريقة ومستوى الري ومعدل اضافة السماد النتروجيني في انتاجية نخيل التمر
[googlepdf url=”https://iraqi-datepalms.net/wp-content
أكمل القراءة »